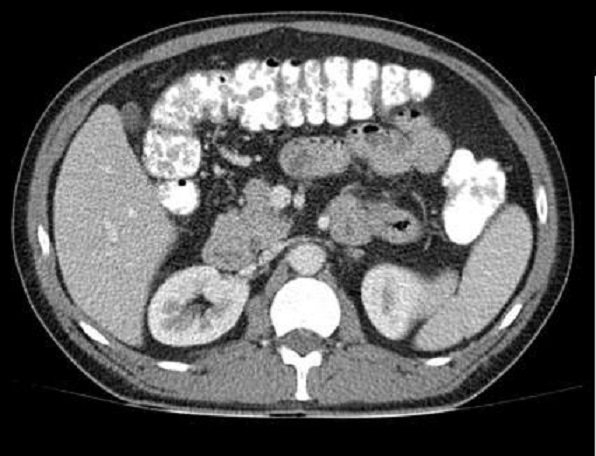

|
Tumeur
du colon :
-
Tumeur begnine du colon :
- Polyps du colon
: Tumeurs begnines du colon et du rectum sont
appeles polypes . Ce sont des excroissances de developpe a
la surface de la paroi interne du colon et du rectum au
niveau de la muqueuse . Il y avait deux difference type de polyps
:
| |
-
Des polyps hyperplasiques n'evoluent
jamais et reste toujour begnin . Ce sont des polyps
hyperplasiques , polyps hamartomateux , polyp lympoide et polyp inflamation . |
| |
- Des polyps qui sont peut d'evoluer et se
transforme progressivement en tumeur
cancereuse : Ce sont des polyps adenomateux . de
veloppe a partir des glandes situes dans la muqueuse
du colon et rectum . L'incidence est 70% des polyps
begnines |
-
Les adenomes du colon ( polyp adenomateuse du
colon ) sont tres petite a moine d'un centimetre de diametre et
reste begnin . La transfomation en cancer presente en moyen
de 10 a 15 ans et incidence de transforme cancereuese est
3/1000.Il y avient quatre type de polyp adenomateuse du
colon :
| |
- L'adenome villeux : presence de 5%
des polyp adenomateuse du colon , en aspect velu
mince , plat evec une base large . Le risque de
transforme en cancer est tres marque |
| |
- Adenome tubulleux : Le plus commun a
incidenece 75% des polyps adenomateux . Ressemble
une champignon a surface est un serie de tubes .
Tres moindre de transforme en cancereuse |
| |
- Adenome tubulovilleux .presence en 20%
des polyps adenomateux . Risque de transforme
en cancer est tres bas. |
| |
- Adenome plan : est une lesion tres
localise de moindre d'un centimetre de diametre .E n
contrairement ademnome plan n'a pas sous forme de
polyp , il est tres plat ( a moindre de 1.3mm de
epaissisement ) et en avait une risque important de
transforme en cancer. |
Sa localisation est sur tout le colon :
Ceacum ( 4% ) , colon ascendante ( 6% ) , Angle colique sous
hepatique 4% , colon trans verse (2% ) , angle colique
gauche ( 8%) , colon descending ( 20% ) , colon sigmoide (
41% ) et rectum ( 23% ) .
Le risque de transforme en cancer des polyps adenomateux
du colon dependent a plusieure de facteurs :
| |
- Le type : L'adenome villeux et adenome
plan avaient plus de risque de transforme en
cancer que les autres |
| |
- La taille : - A moindre de 5mm risque de
transforme en cancer est 0% |
| |
- De 5mm a 9mm le risque de tranforme en cancer est
1-2% |
| |
- De 10-20mm : risque est 10% |
| |
- De plus de 20mm le image de desrisque de developpe en cancer est
de 40-50% |
| |
- Le nombre d'adenomes : Plus de nombre
de adenome problable eleve de risque de
transforme en cancer . |
Aspect radiologique de lavement baryte
mono de contrast et
a double de contrast est : Image en lacule a bord
lisse a sessile ou pedicule . Technique a double de
contrast peut se donne des images de polyp en face anterieure
et posterieure du colon .
| |
 |
|
 |
| |
Aspect laculaire a bord
lisse pedicule d'une polyp du colon ascendant (
fleche rouge ) . Image radiologique de lavement
baryte a mono- contrast du colon . |
|
Image radiologique d'une
polyp du colon sigmoide . Ápect en forme de champignon
du polyp situe au face anterieur du colon avec
pedicule ( fleche rouge ) . Image de lavement du
colon en double de contrast . |
| |
 |
|
 |
| |
Aspect du polyp du colon en
lavement baryte a double de contrast . La polyp
situe en face anterieure du colon et intraluminale
avec de long pedicule . Aspect etre ressemble d'une diverticule du colon
. |
|
Polyp du colon a sessile
intraluminale . Sa bord lisse et sa pied est tres
large . Lavement bayte en double de contrast |
| |
 |
|
 |
| |
Image d'une
polyp a sessile du colon avec pied de tres large . Image typique
d'une ademone villeux du colon a surface irregulier "
cauliflower -like " . Image de lavement baryte en
double de contrast du colon . |
|
Aspect de polyp multiple a
sessile elongation en filiforme du colon ascendant
et transverse . C'est etat inflamation d'une filiforme
polyp du colon |
| |
 |
|

Polypose adenomateuse familiale du colon : Affection
hereditaire cause par la mutation genetique de
deux gene APC et MYH familiale . Aspect radiologique
est particulierement par image de petit polyp en
multiple s'etendre le long du colon |
| |
Image de polyp
multiple du colon transverse et colon descendant
. Lavement baryte en double de contrast . Cliche
decubitus laterale . |
|
Image radiologique de lavement baryte en
double de contrast |
Image macroscopique du colo-scopie
et
image de coloscopie virtuelle d'une polyp du colon :
| |
 |
 |
| |
Aspect coloscopie du polyp
pediculaire du colon . |
Aspect coloscopie du polyp
hyperplasique a sessile du colon (A') , polyp pediculaire ( B') et adenocarcinoma du colon (
C') |
| |
 |
 |
Coloscopievirtuelle
-------Technique
coloscopie a non invasive |
| |
Image d'une polyp a sessile
du colon . Image radiologique coloscopie
virtuelle |
Coloscopie
virtuelle : Image d'une polyp pedicule du colon |
|
Image radiologique TDM
des
polyps du colon est aspect laculaire a sessile ou polypoide
a hyper-dense avec pedicule intra luminal du colon . Sa
nombreuse peut de quelque d'un au colon a multiple
polype s'etendre le long du colon .
| |
 |
|
 |
| |
Aspect du polyp
laculaire hyperdense a bord lisse et a sessile
rehaussement intraluminale du colon ( fleche blanche
) . Image TDM du polyp du colon ean coupe axiale . |
|
Polyp du colon sigmoide en
aspect laculaire a hyperdense situe intraluminale du colon . Sa bord est lisse et en sessile
. Image radiologique TDM en coupe axiale .a travers
S1, S2 . |
| |
 |
|
 |
| |
Image d'une polyp du colon
transverse a aspect polypoide hyper-dense avec une
large pedicule ( fleche blanche ) Polyp du colon
transverse en image radiologique TDM coupe axiale |
|
Aspect polypoide d'une polyp
du colon en coupe axiale du TDM . Image
radiolologique en ce cas est une polyp a petite
pedicule en forme du champignon ( fleche rouge ) |
| |
 |
|
|
| |
Aspect radiologique polypoide multiple du
colon . Image du polyp ét tré nombreuse et s'etendre
le long du colon ascendant , transverse et
descendant . Image radilologique TDM a lavement
baryte du polyp dans ce cas est multiple a
hypo-dense et s'etendre le long de arcade colique .
Maladie polypoide du colon |
|
Même cas en coupe TDM
axiale a travers L2, L3 . Image du polyp dans ce cas
est multiple polypoide a hypodense s'etendre
le long du colon transverse . Image
radiologique TDM du colon avec lavement opaque du
colon . |
| |
|
|
|
Technique radiologique de IRM, TDM , coloscanner ou
coloscopie virtuelle est bien sur les polyps de plus d' un
centimetre de diametre .
Echographie percutanee
avec
lavement de serum isotonique du colon peut eliminer
des polyps a moindre de 7mm de diametre mais cette technique
est a moindre d'utilise que le lavement baryte en double de
contrast
A suivre
Page :
1
/
2
/
3
/
4
/
5
/
6
/
7/
8
<<
PREVIOUS
<<
>> NEXT >>
Gs Bui Binh Tho
|